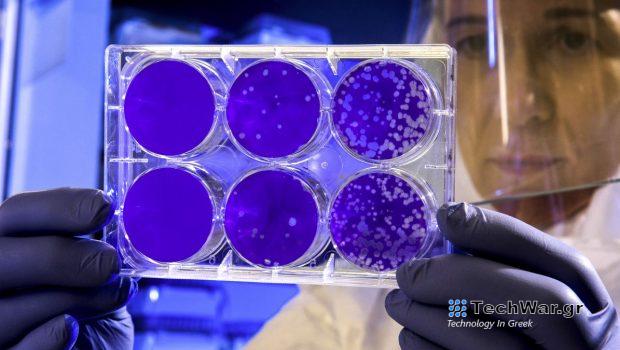
Klebsiella pneumoniae: Προειδοποίηση για θανατηφόρο ανθεκτικό βακτήριο που εξαπλώνεται στην Ευρώπη

Klebsiella pneumoniae: Προειδοποίηση για θανατηφόρο ανθεκτικό βακτήριο που εξαπλώνεται στην Ευρώπη
Βακτήριο που προκαλεί πνευμονία και άλλες σοβαρές λοιμώξεις και είναι ανθεκτικό στα αντιβιοτικά ύστατης λύσης εξαπλώνεται σε χώρες της Ευρώπης, προειδοποιεί το Ευρωπαϊκό Κέντρο Ελέγχου και Πρόληψης Νοσημάτων.
Η Ελλάδα πάντως δεν περιλαμβάνεται στη λίστα.
Μέσα σε τρία χρόνια, ο αριθμός των χωρών όπου έχει εντοπιστεί το ανθεκτικό στέλεχος
του
βακτηρίου
Klebsiella pneumoniae
αυξήθηκε από τις 4 στις 10, ενώ τα επιβεβαιωμένα κρούσματα εκτινάχθηκαν από τα 12 σε 143.
Το
K.pneumoniae
αποτελεί μέρος της φυσιολογικής
μι
κροχλωρίδας του δέρματος, προκαλεί όμως σοβαρές λοιμώξεις αν περάσει στον οργανισμό, ειδικά αν πρόκειται για νοσηλευόμενους ασθενείς ή άτομα σε ανοσοκαταστολή.
Το στέλεχος hvKp ST23 προκαλεί ασυνήθιστα σοβαρή νόσο ακόμα και σε υγιή άτομα
Σε περίπτωση πνευμονίας, η πιθανότητα θανάτου φτάνει το 50% ακόμα και με τη χορήγηση αντιβιοτικών.
Αποικίες Klebsiella pneumoniae σε εργαστηριακή καλλιέργεια (Wikimedia Commons)
Η
προειδοποίηση του ECDC
αφορά ένα συγκεκριμένο στέλεχος του μικροβίου, με την ονομασία hvKp ST23, το οποίο αφενός προκαλεί ασυνήθιστα σοβαρή νόσο, ακόμα και σε υγιή άτομα, αφετέρου είναι ανθεκτικό στις καρβ
απε
νέμες, αντιβιοτικά τελευταίας γραμμής.
«Η πιθανότητα περαιτέρω εξάπλωσης και εδραίωσης σε μονάδες υγείας …. είναι πολύ υψηλή» ανέφερε το ECDC.
Κάτι τέτοιο θα είχε «σημαντικές επιπτώσεις στη θνησιμότητα και θνητότητα» προειδοποίησε.
Πιθανή μετάδοση μεταξύ νοσοκομείων έχει τεκμηριωθεί στην Ιρλανδία (συνολικά 87 κρούσματα) παρά τη λήψη μέτρων. Το ίδιο φαίνεται ότι έχει συμβεί και σε Γαλλία, Λετονία και Λιθουανία.
Οι υπόλοιπες χώρες όπου έχουν αναφερθεί κρούσματα είναι: Δανία,
Φινλανδία
, Ουγγαρία, Ιταλία,
Ολλανδία
και Νορβηγία.
Το ECDC ζητά από τις κυβερνήσεις να βρίσκονται σε επαγρύπνιση και να είναι έτοιμες να επιβεβαιώσουν ενδεχόμενα κρούσματα με γενετικά τεστ.
VIA:
in.gr